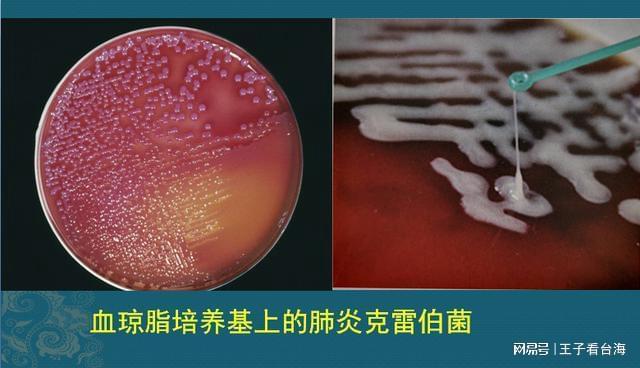
全球新冠肺炎最新实况下的温馨日常观察与记录

摘要:全球新冠肺炎最新实况显示,疫情仍在蔓延。在严峻的疫情之下,人们的温馨日常也愈发珍贵。人们积极应对,保持积极心态,遵守防疫措施,努力让生活回归正常。全球共同抗击疫情,守望相助,展现人类团结的力量。温馨日常虽平凡,却充满希望和温暖。
小明是一个乐观开朗的年轻人,在全球新冠疫情最严重的时候,他始终保持着积极向上的心态,随着疫苗的普及和疫情的缓解,他终于可以走出家门,与好友们相聚,今天是个阳光明媚的日子,小明决定邀请几位好友来家里做客,一起享受这美好的时光。
一大早,小明就开始忙碌起来,他精心准备了一桌丰盛的菜肴,既有母亲传授的家常菜,也有他自己新学的美食,他的朋友们纷纷发来消息,表示正在赶来赴约的路上。
不一会儿,好友小李和小张如约到达,他们一进门就被满桌的菜肴吸引,纷纷夸赞小明的厨艺,他们坐下后,开始分享各自最近的趣事和见闻,小明则谈到了他在疫情期间学会了烹饪和园艺,让家里充满了生机和活力。
门铃突然响起,小明的邻居小王带着自家种的新鲜蔬菜上门拜访,他们一起分享美食和新鲜蔬菜,感慨疫情期间的相互扶持和守望相助。
午餐过后,小明提议大家一起去公园散步,在公园里,他们看到了许多人们正在享受户外运动的乐趣,孩子们在草地上奔跑嬉戏,大人们则悠闲地散步聊天,小明拿出手机播放了全球新冠肺炎最新实况的新闻,他们看到医护人员辛勤工作、疫苗普及进展顺利的画面,感到无比欣慰和自豪。
傍晚时分,小明邀请朋友们一起制作手工饼干和甜点,他们在厨房里忙碌着,一边制作美食一边分享彼此的梦想和未来计划,这个温馨的氛围让家成为了一个充满爱与陪伴的港湾。
夜幕降临,朋友们陆续离开,小明站在门口目送他们远去,感激这场疫情让他们更加珍惜相聚的时光和朋友间的情感纽带,他相信无论未来遇到什么困难和挑战只要心中有爱与陪伴的力量他们都能勇往直前。
这个故事不仅展现全球新冠肺炎最新实况下人们生活的积极面貌还传递了爱与陪伴的信息让我们更加珍惜相聚的时光共同期待美好的未来,同时小明的故事也让我们看到乐观开朗的心态对于面对困难的重要性无论何时我们都要保持积极向上的心态勇往直前。

京公网安备11000000000001号
京公网安备11000000000001号 京ICP备11000001号
京ICP备11000001号